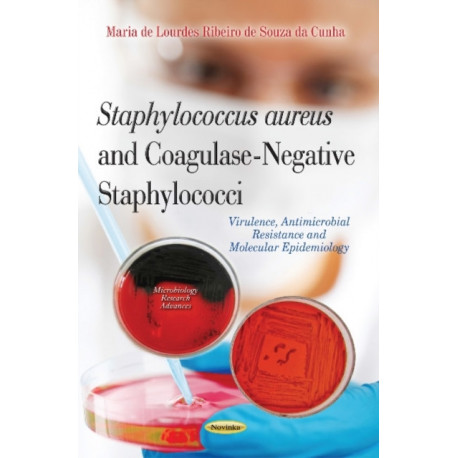
Staphylococcus Aureus & Coagulase-Negative Staphylococci: Virulence, Antimicrobial Resistance & Molecular Epidemiology

Kurv
Vare
varer
(tom)
Ingen varer
Fastlægges senere
Forsendelse
0,- kr
I alt
Staphylococcus Aureus & Coagulase-Negative Staphylococci: Virulence, Antimicrobial Resistance & Molecular Epidemiology
(Bog, Paperback / softback, Engelsk)
Forlag:
Nova Science Publishers Inc
- Type: Bog
- Format: Paperback / softback
-
Sprog:
Engelsk

- ISBN-13: 9781631179389
- Se flere detaljer ▼
Bemærk: Kan ikke garanteres før jul.
Læsernes anmeldelser (0)
Alle detaljer
| Forlag | Nova Science Publishers Inc |
| Forfatter | Maria de Maria de Lourdes Ribeiro de Souza da Cunha |
| Type | Bog |
| Format | Paperback / softback |
| Sprog | Engelsk |
| Udgivelsesdato | 01-09-2014 |
| Første udgivelsesår | 2014 |
| Originalsprog | United States |
| Sideantal | 105 |
| Indbinding | Paperback / softback |
| Forlag | Nova Science Publishers Inc |
| Sideoplysninger | 105 pages |
| Mål | 237 x 168 x 6 |
| ISBN-13 / EAN-13 | 9781631179389 |

